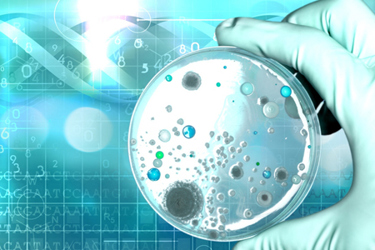
Microbiology laboratory test=GettyImages-849269856

5 Characteristics Of Forward-Thinking Microbiology Labs In 2025
By Tim Sandle, Ph.D.
At times, the microbiology laboratory has lagged behind its chemistry counterpart, and the pharmaceutical function has often been a follower of the clinical laboratory, waiting for technology to mature before considering its implementation rather than being an early adopter.
With cost pressure continuing to be a key factor for pharmaceutical organizations, and with some laboratory functions considered to be resource drains as opposed to value-adding, interest in improving microbiology laboratory efficiency remains high. This article assesses five trends that are likely to be part of this cost and efficiency focus during 2025.
1. Automation Of The Laboratory Workspace
Automation of microbiology laboratory methods is one of the design elements of rapid microbiological methods (in addition to improved accuracy and a faster time to result). While many rapid methods have been oriented to end-product testing, there remain many other laboratory activities that could be subject to automation.
Automation is of value when it reduces manual activity, especially activities that are slow, repetitive, prone to error, and do not require significant human analysis. An obvious area is traditional microbiology culture, including plate or broth inoculation and incubation, followed by inspection for colony formation. Such activities represent a substantial portion of laboratory labor.1
Automation of such processes is of potential benefit to large and midsize laboratories. Robotic solutions have been available within the clinical microbiology area for several years;2 these smaller-scale solutions are being upscaled for larger laboratories and they may begin to become more commonplace within the pharmaceutical laboratory. An important consideration is how these sometimes disparate technologies can be put together to create a harmonized laboratory workflow.
It is likely that plate-reading technologies will continue to advance. There are two types of automatic colony counters: digital counters, which are more precisely semi-automatic, since an analyst is required to identify and probe the colony, and automatic counters that use laser scanning and digital imaging to capture and interpret colony images.3
2. Improving Microbial Identification Outcomes With AI
Many microbiology laboratories have adopted the proteomic identification method MALDI-TOF. The technology works by crystallizing the organism in an organic acid matrix. A laser ionizes the sample within the matrix and this produces singly protonated sample ions, which are accelerated through a vacuum. The speed at which the ions travel across the vacuum creates a pattern unique to a given organism.
Reasons for adoption are based on the time to result, improved throughput (via workflow optimization), and ease of use. No identification system has an unlimited database, and the absence of specific species leads to either no identification or a misidentification being obtained. However, data is still produced, and several laboratories have turned to artificial intelligence to interpret MALDI-ToF MS spectra.4 The analysis is based on machine learning relating to technologies like support vector machines, genetic algorithms, artificial neural networks, and quick classifiers. These approaches use nonlinear mapping of input vectors to best represent the data based on a characterizing collection of data features. These approaches also can be used for interpreting antimicrobial susceptibility testing.
3. Sensing Pathogens
Municipal water providers have experimented with biosensors in water supplies to detect specific pathogens. While the pharmaceutical sector has experimented with flow cytometry to detect microbial numbers in circulating water systems, such technology does not provide an indication of specific species. The main recourse is to cultivation-based assays, which are time-consuming and susceptible to false positives and negatives.
Such insights can be revealed through on-site filtration of large water volumes (up to 1,000 liters) using ultrafiltration membrane modules. A suitable method of analysis is viability quantitative PCR (qPCR) with propidium monoazide (a photoreactive DNA-binding dye that preferentially binds to double-stranded DNA). This method involves sequencing PCR-amplified gene fragments to analyze the microbial communities obtained. The role of the dye is to neutralize the DNA of dead cells, leading to only the DNA from live microbial cells being detected.5 qPCR assays are unaffected by the cultivability of the target organism, providing far greater information about the nature of a water system.
Results from separative ultrafiltration membrane modules can aid improved understanding of the microbial ecology of water distribution systems.6
4. Virtual Reality Training
A clear path toward improving efficiency is through competency development and improved training. Having effectively trained staff improves processing times and helps to lower error occurrence. Virtual reality can play a role, especially during initial training before the trainee begins to manage samples of value.
Using computer technology to create virtual reality (VR) microbiology laboratories provides a new pedagogical approach to improve learning and help to develop psychomotor skills. As an example of what is possible, researchers at the International Medical University, Kuala Lumpur, produced a VR-based microbiology laboratory on a head-mounted display (HMD): an interactive three-dimensional VR laboratory with a 360-degree view designed to replicate the physical laboratory environment. The initial trial using the VR laboratory involved six microbiology experiments on Gram staining, bacterial streaking, bacterial motility, catalase testing, oxidase testing, and biochemical tests. By using the immersive learning experience, trainees were able to repeat each experiment multiple times without the real-world impact of mistakes and mishaps.7 Similarly, the U.S. CDC has deployed VR training to instruct personnel in the use of microbiological safety cabinets, including how to prepare for work, apply safe-work practices, and how to decontaminate and shut down devices.8
5. Promoting The Green Agenda
Microbiology laboratories use and dispose of copious quantities of plastics. Traditionally, plastics have been used to manufacture common consumables like Petri dishes, culture loops, and dilution tubes. The continued development curve for single-use, sterile disposable technologies introduces both advantages for laboratory flexibility and adds to the burden of plastic waste disposal and the deleterious effects on the environment. Laboratories consume 10 times more energy and four times more water than commercial office spaces, generating over 6.1 tons of plastic waste annually.9
It is unlikely there will be any reversal back to glassware; however, some more ecologically minded laboratories are developing ways to decontaminate and reuse plastic equipment of the type that would usually be thrown away after one use.10
As an example, the University of Edinburgh’s microbiology department developed a method for chemically decontaminating the plastic tubes before a second level of decontamination under heat and pressure. Through this, a trial demonstrated how 1,670 plastic test tubes and 1,300 culture loops could be reused over a four-week period. This activity led to a 43-kilogram reduction in waste.11
As awareness increases, the trend over the next few years may see more funding agencies incentivizing good environmental practice by allocating a portion of research grant budgets toward reuse and recycling facilities within the laboratory.
References
- Dauwalder O, Landrieve L, Laurent F, et al. 2016. Does bacteriology laboratory automation reduce time to results and increase quality management? Clin Microbiol Infect 22:236–243
- Murray, P. R. Laboratory automation impact on antimicrobial resistance. Micro Austr 2019; 336 (40): 66-68
- Glasson J, Hill R, Summerford M, et al. 2017. Multicenter evaluation of an image analysis device (APAS): comparison between digital image and traditional plate reading using urine cultures. Ann Lab Med 37:499–504
- Fissel, J. Enter the Matrix: An Update on MALDI-ToF MS Advancements through 2024, Clinical Microbiology Newsletter, 2024; 46: 22-26
- Nocker A, Sossa-Fernandez P, Burr MD, Camper AK. 2007. Use of propidium monoazide for live/dead distinction in microbial ecology. Appl Environ Microbiol 73:5111–5117
- Hozalski RM, Zhao X, Kim T, LaPara TM. 2024. On-site filtration of large sample volumes improves the detection of opportunistic pathogens in drinking water distribution systems. Appl Environ Microbiol 90:e01658-23
- Chitra, E., Mubin, S.A., Nadarajah, V.D. et al. A 3-D interactive microbiology laboratory via virtual reality for enhancing practical skills. Sci Rep 14, 12809 (2024). https://doi.org/10.1038/s41598-024-63601-y
- U.S. Centers for Disease Control and Prevention. Virtual Reality Laboratory Training, September 2024: https://www.cdc.gov/lab-training/php/virtual-reality/index.html
- DeForce, E. Taking Action Toward More Sustainable Science, Laboratory Manager, August 2021: https://www.labmanager.com/taking-action-toward-more-sustainable-science-26468
- Urbina, M., Watts, A., Reardon, E. Environment: Labs should cut plastic waste too. Nature, 2015; 528 (7583): 479 DOI: 10.1038/528479c
- Alves, J., Sargison, F., Stawarz, H. et al. A case report: insights into reducing plastic waste in a microbiology laboratory. Access Microbiology, 2020; DOI: 10.1099/acmi.0.000173
About The Author:
Tim Sandle, Ph.D., is a pharmaceutical professional with wide experience in microbiology and quality assurance. He is the author of more than 30 books relating to pharmaceuticals, healthcare, and life sciences, as well as over 170 peer-reviewed papers and some 500 technical articles. Sandle has presented at over 200 events and he currently works at Bio Products Laboratory Ltd. (BPL), and he is a visiting professor at the University of Manchester and University College London, as well as a consultant to the pharmaceutical industry. Visit his microbiology website at https://www.pharmamicroresources.com.